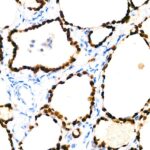

TTF1 Rabbit mAb (A22248)
$148.00 – $548.00
Abclonal TTF1 Rabbit mAb (Catalog Number: A22248) encodes a protein initially identified as a thyroid-specific transcription factor.
- Details & Specifications
- References
| Catalog No. | A22248 |
|---|---|
| Product Name | TTF1 Rabbit mAb (A22248) |
| Supplier Name | ABclonal, Inc. |
| Brand Name | Abclonal |
| Synonyms | BCH; BHC; NK-2; TEBP; TTF1; NKX2A; NMTC1; T/EBP; TITF1; TTF-1; NKX2.1 |
| Gene Name | NKX2-1 |
| Protein Name | NKX2-1 |
| Uniprot/Swissprot ID | P43699 |
| Gene ID | 7080 |
| Clone | ARC2744 |
| Clonality | Monoclonal |
| Source/Host | Rabbit |
| Reactivity | Human, Mouse, Rat |
| Conjugate | Unconjugated |
| Note | Products will be shipped from the warehouse in Massachusetts. Promotion is running from time to time. Welcome to send a request for quote to message@sydlabs.com. |
| Order Offline | Syd Labs, Inc. 4 Avenue E, Hopkinton, MA 01748 USA. Phone: 1-617-401-8149 Fax: 1-617-606-5019 Email: message@sydlabs.com |
Description
A22248: TTF1 Rabbit mAb
This gene encodes a protein initially identified as a thyroid-specific transcription factor. The encoded protein binds to the thyroglobulin promoter and regulates the expression of thyroid-specific genes but has also been shown to regulate the expression of genes involved in morphogenesis. Mutations and deletions in this gene are associated with benign hereditary chorea, choreoathetosis, congenital hypothyroidism, and neonatal respiratory distress, and may be associated with thyroid cancer. Multiple transcript variants encoding different isoforms have been found for this gene. This gene shares the symbol/alias ‘TTF1’ with another gene, transcription termination factor 1, which plays a role in ribosomal gene transcription.
Immunogen Information about TTF1 Rabbit mAb (A22248)
Immunogen:Recombinant protein of human NKX2-1
Sequence:MSMSPKHTTPFSVSDILSPLEESYKKVGMEGGGLGAPLAAYRQGQAAPPTAAMQQHAVGHHGAVTAAYHMTAAGVPQLSHSAVGGYCNGNLGNMSELPPY
Gene ID:7080
Swiss prot:P43699
Synonyms:BCH; BHC; NK-2; TEBP; TTF1; NKX2A; NMTC1; T/EBP; TITF1; TTF-1; NKX2.1
Calculated MW:39kDa
Observed MW:Refer to figures
Images of TTF1 Rabbit mAb (A22248)

Immunohistochemistry analysis of paraffin-embedded Human lung adenocarcinoma using NKX2-1 Rabbit mAb (A22248) at dilution of 1:100 (40x lens).Perform high pressure antigen retrieval with 10 mM citrate buffer pH 6.0 before commencing with IHC staining protocol.

Immunohistochemistry analysis of paraffin-embedded human thyroid cancer using NKX2-1 Rabbit mAb (A22248) at dilution of 1:100 (40x lens).Perform high pressure antigen retrieval with 10 mM citrate buffer pH 6.0 before commencing with IHC staining protocol.

Immunohistochemistry analysis of paraffin-embedded human thyroid using NKX2-1 Rabbit mAb (A22248) at dilution of 1:100 (40x lens).Perform high pressure antigen retrieval with 10 mM citrate buffer pH 6.0 before commencing with IHC staining protocol.

Immunohistochemistry analysis of paraffin-embedded mouse lung using NKX2-1 Rabbit mAb (A22248) at dilution of 1:100 (40x lens).Perform high pressure antigen retrieval with 10 mM citrate buffer pH 6.0 before commencing with IHC staining protocol.
Please remember our product information: TTF1 Rabbit mAb (Catalog Number: A22248) Abclonal